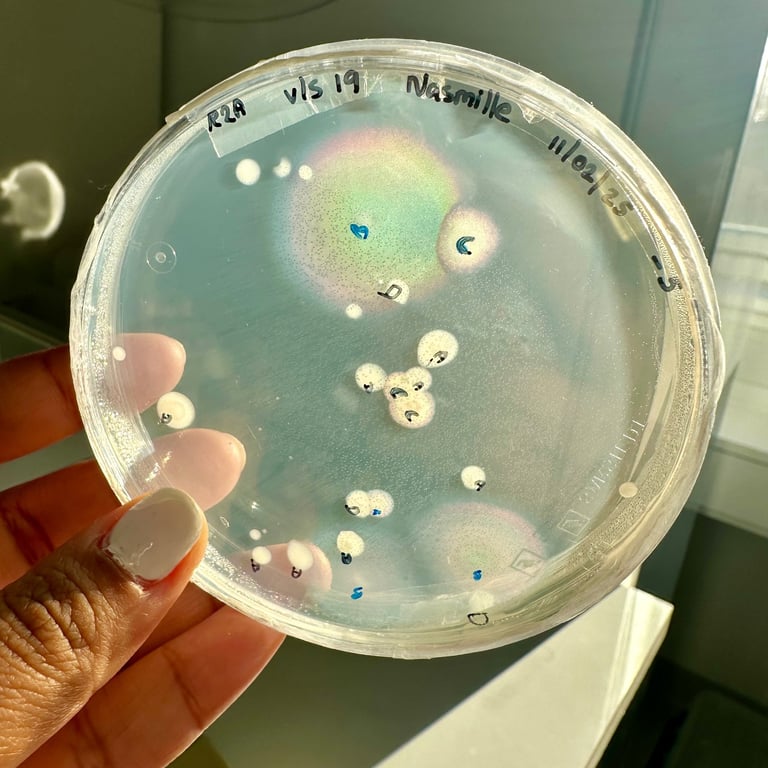
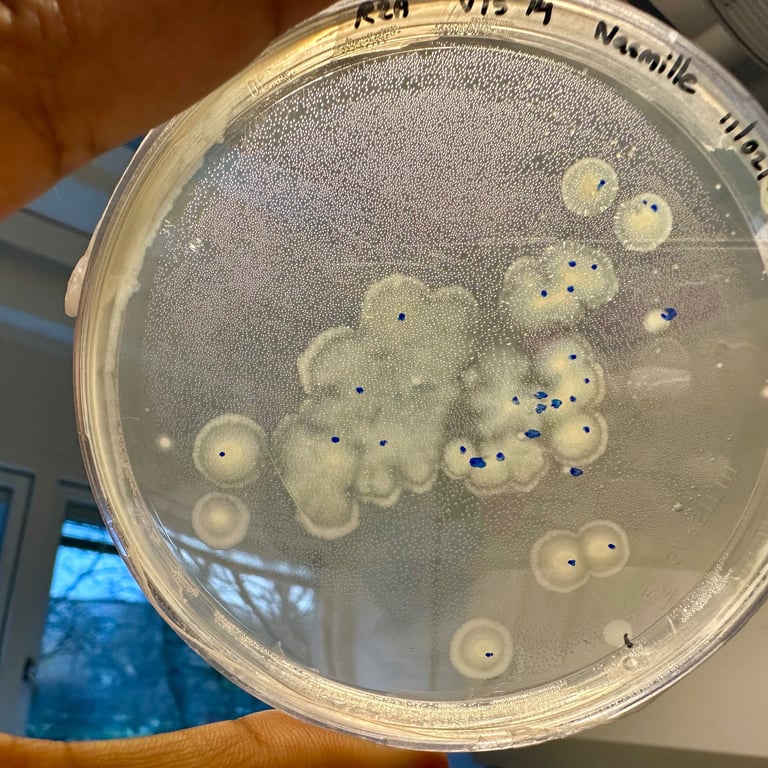
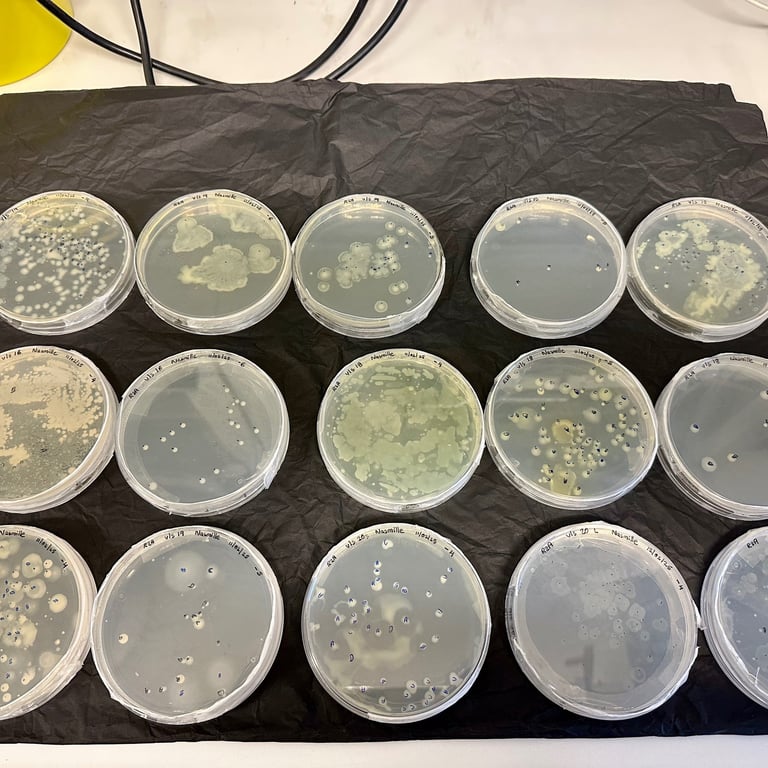

Looking Back at 2025: Science, Growth, and Belonging
A reflective look back at 2025 — a year of professional consolidation, growing independence as a scientist, and the personal moments that shaped it, written on a snowy day in Copenhagen.
1/5/20262 min read


Today Copenhagen is covered in snow, and the quiet has made it easier to look back at 2025 with some perspective. It has been a fulfilling year — intellectually demanding, professionally stretching, and, in ways I didn’t fully anticipate, grounding.
When I think about this year, I don’t think first about outputs or milestones (I'll leave those for the CV). I think about a shift in how I relate to my work. For much of my career, I was building towards independence — gaining expertise, contributing to large projects, learning how research ecosystems function. In 2025, that preparation turned into practice. Leading my own project meant making decisions daily, often with incomplete information, and taking responsibility not just for the science, but for the people and ideas connected to it.
That responsibility reshaped my confidence in quiet ways. I became more comfortable trusting my scientific judgement, articulating a clear research direction, and standing behind it. This fellowship has been central to that transition. It gave me the space to think carefully, to design research with intention, and to mentor students and work closely with colleagues — I've enjoyed watching them grow and succeed alongside the project itself.
This year was also shaped by moments beyond the lab. Sampling in Bøllemosen with my daughter (you can see her with her bag full of moss below), seeing her become fluent in Danish, sharing fieldwork and creative projects with inspiring and supportive colleagues, building the Arctic Bear game with the VOLT team, and travelling to Abisko this summer — these experiences reminded me that growth is rarely confined to one space and its much more enjoyable with good company. Visits from UK friends added to that sense of connection across places.
One particularly meaningful milestone was writing my last paper with my mentor — a quiet closing of a long chapter of training and collaboration. The preprint, Structural and evolutionary insights into the isoprene monooxygenases, is now available here: https://doi.org/10.5281/zenodo.18141782.
As I move into the final nine months of my MSCA fellowship, I feel grateful rather than rushed. There is time to publish, to refine ideas, write new proposals, and to strengthen collaborations — and to do so thoughtfully.
On a snowy day like today, looking back brings reassurance. 2025 helped me consolidate not only my research direction, but my identity as an independent scientist — still evolving, but firmly rooted.

Nasmille Larke-Mejía Research
Exploring microbes' roles in environmental sustainability.
CONTACT ME:
© 2024. All rights reserved.
info@nasmillelarkemejia.com
Disclaimer: Some images and text on this website, including proofreading, have been created or refined using AI tools. For inquiries or further information, please contact me.